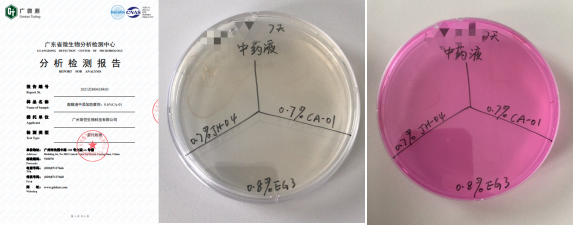
中藥液防腐

中藥液相比面膜、精華在防腐這環節是比較復雜的,因為中藥材成分比較復雜并非所有防腐劑都可以使用,當與防腐劑配伍不好容易導致分層、腐臭或導致產品失效。防腐工作難度高,某個公司使用了很多品牌的防腐劑都出現上述以上問題。
簡愷生物選用了三款防腐劑與該公司的中藥液做防腐挑戰實驗,在防腐挑戰第 7天細菌和霉菌都通過了,在防腐挑戰28天產品沒有出現分層、發臭等情況。
為什么簡愷生物這家防腐劑廠家選用了三款防腐劑都能解決了中藥液的防腐問題?
1.
所有防腐劑都是由具有15年防腐劑行業資深工程帶領團隊研發而成的。
2.
所有防腐劑都通過了產品指標測試、防腐挑戰測試(同時測不同的基質)、穩定性測試、MIC值測試、化妝品刺激性的測評、殺菌率測試等項目后才投入生產、銷售。
3.
原料用具有資質的生產廠家,每批原料經過嚴格的測試合格后投入使用。新原料經過技術評估后合格后方可列入原料供應商名單。
4.
防腐劑送廣東省微生物分析檢驗中心進行檢測,檢測結果均通過。
綜合上述,一款具有配溫和、伍性好、高效廣譜不管從研發、原料、生產都需嚴格管控。
【本文標簽】 成分復雜的中藥液用什么防腐劑可以有效防腐并不出現分層、失效?
【責任編輯】